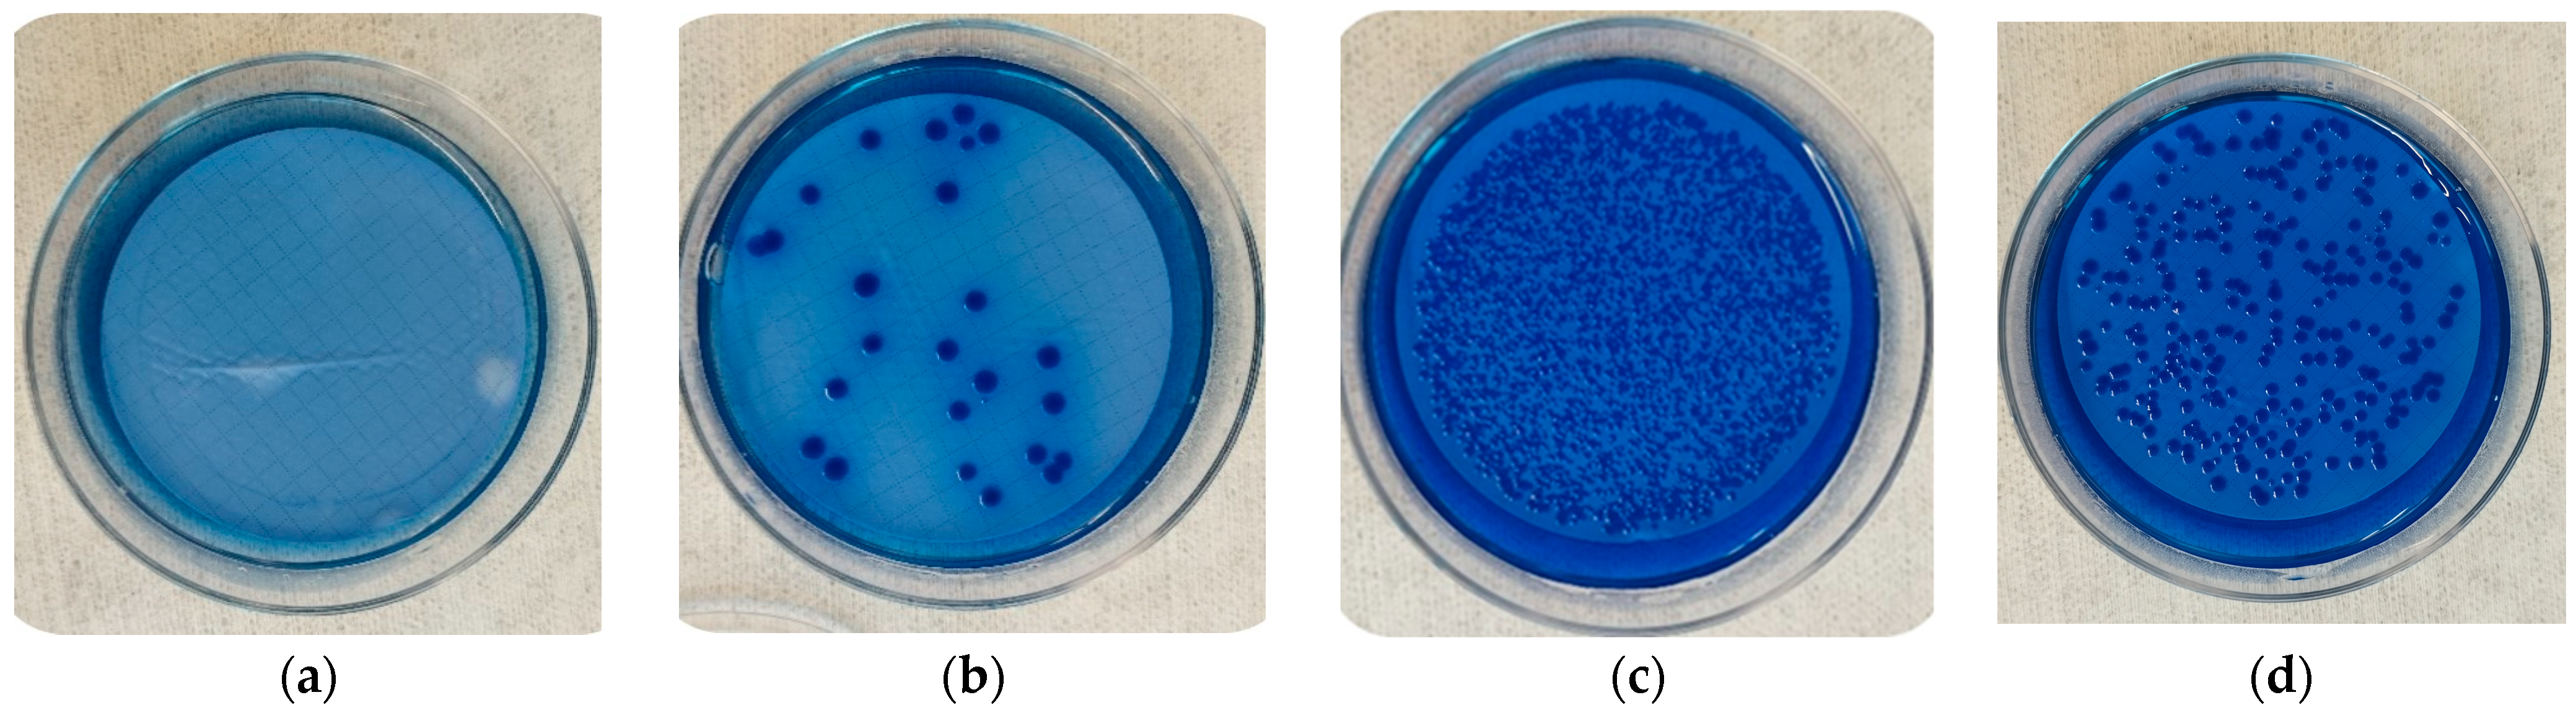
Microorganisms 12 00243 g002

Relationship between Desiccation Tolerance and Biofilm Formation in Shiga Toxin-Producing Escherichia coli
Abstract
1. Introduction
2. Materials and Methods
2.1. Selection of Isolates
2.2. Preparation of Relative Humidity Tubes
2.3. Coupon Preparation
2.4. Bacterial Culture Conditions
2.5. Inoculation and Incubation of Stainless Steel Coupons
2.6. Assessment of Bacterial Counts
2.7. DNA Extraction and PCR Confirmation
2.8. Statistical Analysis
3. Results
3.1. Colony Morphology
3.2. Effects of Temperature and Relative Humidity
3.3. Effects of Biofilm-Producing Ability
3.4. Effects of Desiccation on STEC as Compared to Generic E. coli
4. Discussion
4.1. Atypical Colony Morphology
4.2. Effects of Temperature and Relative Humidity
4.3. Effects of Biofilm-Forming Class
4.4. Effects of Desiccation on STEC vs. Generic E. coli
4.5. Is Desiccation a Potentially Useful Antimicrobial Hurdle for Beef Slaughter Plants?
5. Conclusions
Author Contributions
Funding
Data Availability Statement
Acknowledgments
Conflicts of Interest
References
- Aklilu, A.; Kahase, D.; Dessalegn, M.; Tarekegn, N.; Gebremichael, S.; Zenebe, S.; Desta, K.; Mulugeta, G.; Mamuye, Y.; Mama, M. Prevalence of Intestinal Parasites, Salmonella and Shigella among Apparently Health Food Handlers of Addis Ababa University Student’s Cafeteria, Addis Ababa, Ethiopia. BMC Res. Notes 2015, 8, 17. [Google Scholar] [CrossRef] [PubMed]
- Hemalata, V.B.; Virupakshaiah, D.B.M. Isolation and Identification of Food Borne Pathogens from Spoiled Food Samples. Int. J. Curr. Microbiol. Appl. Sci. 2016, 5, 1017–1025. [Google Scholar] [CrossRef]
- Kolling, G.; Wu, M.; Guerrant, R.L. Enteric Pathogens through Life Stages. Front. Cell Infect. Microbiol. 2012, 2, 114. [Google Scholar] [CrossRef]
- Zhao, X.; Lin, C.-W.; Wang, J.; Oh, D.H. Advances in Rapid Detection Methods for Foodborne Pathogens. J. Microbiol. Biotechnol. 2014, 24, 297–312. [Google Scholar] [CrossRef] [PubMed]
- Majowicz, S.E.; Scallan, E.; Jones-Bitton, A.; Sargeant, J.M.; Stapleton, J.; Angulo, F.J.; Yeung, D.H.; Kirk, M.D. Global Incidence of Human Shiga Toxin Producing E. coli Infections and Deaths: A Systematic Review and Knowledge Synthesis. Foodborne Pathog. Dis. 2014, 11, 447–455. [Google Scholar] [CrossRef] [PubMed]
- Wells, M. Shiga Toxigenic Escherichia coli Biofilm Persistence in Beef Processing Environments and Contamination of Beef; University of Manitoba: Winnipeg, MB, Canada, 2021. [Google Scholar]
- Bintsis, T. Foodborne Pathogens. AIMS Microbiol. 2017, 3, 529–563. [Google Scholar] [CrossRef] [PubMed]
- Wang, R.; Luedtke, B.E.; Bosilevac, J.M.; Schmidt, J.W.; Kalchayanand, N.; Arthur, T.M. Escherichia coli O157:H7 Strains Isolated from High-Event Period Beef Contamination Have Strong Biofilm-Forming Ability and Low Sanitizer Susceptibility, Which Are Associated with High PO157 Plasmid Copy Number. J. Food Prot. 2016, 79, 1875–1883. [Google Scholar] [CrossRef]
- Moser, C.; Jensen, P.Ø.; Thomsen, K.; Kolpen, M.; Rybtke, M.; Lauland, A.S.; Trøstrup, H.; Tolker-Nielsen, T. Immune Responses to Pseudomonas aeruginosa Biofilm Infections. Front. Immunol. 2021, 12, 625597. [Google Scholar] [CrossRef]
- Ribeiro, M.M.; Graziano, K.U.; Olson, N.; França, R.; Alfa, M.J. The Polytetrafluoroethylene (PTFE) Channel Model of Cyclic-Buildup Biofilm and Traditional Biofilm: The Impact of Friction, and Detergent on Cleaning and Subsequent High-Level Disinfection. Infect. Control Hosp. Epidemiol. 2020, 41, 172–180. [Google Scholar] [CrossRef]
- Stanford, K.; Tran, F.; Zhang, P.; Yang, X. Biofilm-Forming Capacity of Escherichia coli Isolated from Cattle and Beef Packing Plants: Relation to Virulence Attributes, Stage of Processing, Antimicrobial Interventions, and Heat Tolerance. Appl. Environ. Microbiol. 2021, 87, e01126-21. [Google Scholar] [CrossRef]
- Winfield, M.D.; Groisman, E.A. Role of Nonhost Environments in the Lifestyles of Salmonella and Escherichia coli. Appl. Environ. Microbiol. 2003, 69, 3687–3694. [Google Scholar] [CrossRef] [PubMed]
- Yu, T.; Ma, M.; Sun, Y.; Xu, X.; Qiu, S.; Yin, J.; Chen, L. The Effect of Sublethal Concentrations of Benzalkonium Chloride on the LuxS/AI-2 Quorum Sensing System, Biofilm Formation and Motility of Escherichia coli. Int. J. Food Microbiol. 2021, 353, 109313. [Google Scholar] [CrossRef] [PubMed]
- Burt, S. Essential Oils: Their Antibacterial Properties and Potential Applications in Foods—A Review. Int. J. Food Microbiol. 2004, 94, 223–253. [Google Scholar] [CrossRef] [PubMed]
- Maszewska, A.; Moryl, M.; Wu, J.; Liu, B.; Feng, L.; Rozalski, A. Amikacin and Bacteriophage Treatment Modulates Outer Membrane Proteins Composition in Proteus mirabilis Biofilm. Sci. Rep. 2021, 11, 1522. [Google Scholar] [CrossRef] [PubMed]
- Seghal Kiran, G.; Nishanth Lipton, A.; Kennedy, J.; Dobson, A.D.; Selvin, J. A Halotolerant Thermostable Lipase from the Marine Bacterium Oceanobacillus Sp. PUMB02 with an Ability to Disrupt Bacterial Biofilms. Bioengineered 2014, 5, 305–318. [Google Scholar] [CrossRef] [PubMed]
- Salisbury, A.-M.; Mullin, M.; Foulkes, L.; Chen, R.; Percival, S.L. The Ability of a Concentrated Surfactant Gel to Reduce an Aerobic, Anaerobic and Multispecies Bacterial Biofilm in Vitro. In Advances in Microbiology, Infectious Diseases and Public Health; Springer International Publishing: Cham, Switzerland, 2021; pp. 149–157. [Google Scholar]
- Bigelow, T.A.; Northagen, T.; Hill, T.M.; Sailer, F.C. Ultrasound Histotripsy and the Destruction of Escherichia coli Biofilms. In Proceedings of the 2008 30th Annual International Conference of the IEEE Engineering in Medicine and Biology Society, Vancouver, BC, Canada, 20–25 August 2008; IEEE: Piscataway, NJ, USA, 2008; pp. 4467–4470. [Google Scholar]
- Oulahal-Lagsir, N.; Martial-Gros, A.; Boistier, E.; Blum, L.J.; Bonneau, M. The Development of an Ultrasonic Apparatus for the Non-Invasive and Repeatable Removal of Fouling in Food Processing Equipment. Lett. Appl. Microbiol. 2000, 30, 47–52. [Google Scholar] [CrossRef]
- Yu, H.; Liu, Y.; Li, L.; Guo, Y.; Xie, Y.; Cheng, Y.; Yao, W. Ultrasound-Involved Emerging Strategies for Controlling Foodborne Microbial Biofilms. Trends Food Sci. Technol. 2020, 96, 91–101. [Google Scholar] [CrossRef]
- Ravikumar, K.; Basu, B.; Dubey, A.K. Analysis of Electrical Analogue of a Biological Cell and Its Response to External Electric Field. Regen. Eng. Transl. Med. 2019, 5, 10–21. [Google Scholar] [CrossRef]
- Sabelnikov, A.G.; Cymbalyuk, E.S.; Gongadze, G.; Borovyagin, V.L. Escherichia coli Membranes during Electrotransformation: An Electron Microscopy Study. Biochim. Biophys. Acta BBA Biomembr. 1991, 1066, 21–28. [Google Scholar] [CrossRef]
- Desmond, E. Reducing Salt: A Challenge for the Meat Industry. Meat Sci. 2006, 74, 188–196. [Google Scholar] [CrossRef]
- Csonka, L.N. Physiological and Genetic Responses of Bacteria to Osmotic Stress. Microbiol. Rev. 1989, 53, 121–147. [Google Scholar] [CrossRef] [PubMed]
- Rahman, M.S. Handbook of Food Preservation, 2nd ed.; CRC Press: Boca Raton, FL, USA, 2007; ISBN 9780429191084. [Google Scholar]
- Maule, A. Survival of Verocytotoxigenic Escherichia coli O157 in Soil, Water and on Surfaces. J. Appl. Microbiol. 2000, 88, 71S–78S. [Google Scholar] [CrossRef] [PubMed]
- Wilks, S.A.; Michels, H.; Keevil, C.W. The Survival of Escherichia coli O157 on a Range of Metal Surfaces. Int. J. Food Microbiol. 2005, 105, 445–454. [Google Scholar] [CrossRef] [PubMed]
- Visvalingam, J.; Liu, Y.; Yang, X. Impact of Dry Chilling on the Genetic Diversity of Escherichia coli on Beef Carcasses and on the Survival of E. coli and E. coli O157. Int. J. Food Microbiol. 2017, 244, 62–66. [Google Scholar] [CrossRef] [PubMed]
- Zhang, P.; Tran, F.; Stanford, K.; Yang, X. Are Antimicrobial Interventions Associated with Heat-Resistant Escherichia coli on Meat? Appl. Environ. Microbiol. 2020, 86, e00512-20. [Google Scholar] [CrossRef] [PubMed]
- Tsai, Y.L.; Palmer, C.J.; Sangermano, L.R. Detection of Escherichia coli in Sewage and Sludge by Polymerase Chain Reaction. Appl. Environ. Microbiol. 1993, 59, 353–357. [Google Scholar] [CrossRef] [PubMed]
- Bej, A.K.; DiCesare, J.L.; Haff, L.; Atlas, R.M. Detection of Escherichia coli and Shigella Spp. in Water by Using the Polymerase Chain Reaction and Gene Probes for Uid. Appl. Environ. Microbiol. 1991, 57, 1013–1017. [Google Scholar] [CrossRef]
- Pinto, C.; Melo-Miranda, R.; Gordo, I.; Sousa, A. The Selective Advantage of the Lac Operon for Escherichia coli Is Conditional on Diet and Microbiota Composition. Front. Microbiol. 2021, 12, 709259. [Google Scholar] [CrossRef]
- Fujikawa, H.; Akimoto, R. New Blue Pigment Produced by Pantoea agglomerans and Its Production Characteristics at Various Temperatures. Appl. Environ. Microbiol. 2011, 77, 172–178. [Google Scholar] [CrossRef]
- Brouwer, A.F.; Eisenberg, M.C.; Love, N.G.; Eisenberg, J.N.S. Phenotypic Variations in Persistence and Infectivity between and within Environmentally Transmitted Pathogen Populations Impact Population-Level Epidemic Dynamics. BMC Infect. Dis. 2019, 19, 449. [Google Scholar] [CrossRef]
- Boor, K.J. Bacterial Stress Responses: What Doesn’t Kill Them Can Make Them Stronger. PLoS Biol. 2006, 4, e23. [Google Scholar] [CrossRef] [PubMed]
- Ezraty, B.; Gennaris, A.; Barras, F.; Collet, J.-F. Oxidative Stress, Protein Damage and Repair in Bacteria. Nat. Rev. Microbiol. 2017, 15, 385–396. [Google Scholar] [CrossRef] [PubMed]
- Guan, N.; Li, J.; Shin, H.; Du, G.; Chen, J.; Liu, L. Microbial Response to Environmental Stresses: From Fundamental Mechanisms to Practical Applications. Appl. Microbiol. Biotechnol. 2017, 101, 3991–4008. [Google Scholar] [CrossRef] [PubMed]
- Mihaljevic, R.R.; Sikic, M.; Klancnik, A.; Brumini, G.; Mozina, S.S.; Abram, M. Environmental Stress Factors Affecting Survival and Virulence of Campylobacter jejuni. Microb. Pathog. 2007, 43, 120–125. [Google Scholar] [CrossRef]
- Pinto, A.C.; de Sá, P.H.C.G.; Ramos, R.T.J.; Barbosa, S.; Barbosa, H.P.M.; Ribeiro, A.C.; Silva, W.M.; Rocha, F.S.; Santana, M.P.; de Paula Castro, T.L.; et al. Differential Transcriptional Profile of Corynebacterium pseudotuberculosis in Response to Abiotic Stresses. BMC Genom. 2014, 15, 14. [Google Scholar] [CrossRef] [PubMed]
- de Goffau, M.C.; Yang, X.; van Dijl, J.M.; Harmsen, H.J.M. Bacterial Pleomorphism and Competition in a Relative Humidity Gradient. Environ. Microbiol. 2009, 11, 809–822. [Google Scholar] [CrossRef] [PubMed]
- Janning, B.; in’t Veld, P.H. Susceptibility of Bacterial Strains to Desiccation: A Simple Method to Test Their Stability in Microbiological Reference Materials. Anal. Chim. Acta 1994, 286, 469–476. [Google Scholar] [CrossRef]
- Kramer, A.; Schwebke, I.; Kampf, G. How Long Do Nosocomial Pathogens Persist on Inanimate Surfaces? A Systematic Review. BMC Infect. Dis. 2006, 6, 130. [Google Scholar] [CrossRef]
- Suehr, Q.J.; Chen, F.; Anderson, N.M.; Keller, S.E. Effect of Ph on Survival of Escherichia coli O157, Escherichia coli O121, and Salmonella enterica during Desiccation and Short-Term Storage. J. Food Prot. 2020, 83, 211–220. [Google Scholar] [CrossRef]
- Hwang, C.-A.; Porto-Fett, A.C.S.; Juneja, V.K.; Ingham, S.C.; Ingham, B.H.; Luchansky, J.B. Modeling the Survival of Escherichia coli O157:H7, Listeria monocytogenes, and Salmonella typhimurium during Fermentation, Drying, and Storage of Soudjouk-Style Fermented Sausage. Int. J. Food Microbiol. 2009, 129, 244–252. [Google Scholar] [CrossRef]
- Nissen, H.; Holck, A. Survival of Escherichia coli O157:H7, Listeria monocytogenes and Salmonella kentucky in Norwegian Fermented, Dry Sausage. Food Microbiol. 1998, 15, 273–279. [Google Scholar] [CrossRef]
- Chikthimmah, N.; Knabel, S.J. Survival of Escherichia coli O157:H7, Salmonella typhimurium, and Listeria monocytogenes in and on Vacuum Packaged Lebanon Bologna Stored at 3.6 and 13.0 °C. J. Food Prot. 2001, 64, 958–963. [Google Scholar] [CrossRef] [PubMed]
- Ishii, S.; Ksoll, W.B.; Hicks, R.E.; Sadowsky, M.J. Presence and Growth of Naturalized Escherichia coli in Temperate Soils from Lake Superior Watersheds. Appl. Environ. Microbiol. 2006, 72, 612–621. [Google Scholar] [CrossRef] [PubMed]
- Ishii, S.; Yan, T.; Vu, H.; Hansen, D.L.; Hicks, R.E.; Sadowsky, M.J. Factors Controlling Long-Term Survival and Growth of Naturalized Escherichia coli Populations in Temperate Field Soils. Microbes Environ. 2010, 25, 8–14. [Google Scholar] [CrossRef] [PubMed]
- Whitman, R.L.; Shively, D.A.; Pawlik, H.; Nevers, M.B.; Byappanahalli, M.N. Occurrence of Escherichia coli and Enterococci in Cladophora (Chlorophyta) in Nearshore Water and Beach Sand of Lake Michigan. Appl. Environ. Microbiol. 2003, 69, 4714–4719. [Google Scholar] [CrossRef] [PubMed]
- Coleri Cihan, A.; Karaca, B.; Ozel, B.P.; Kilic, T. Determination of the Biofilm Production Capacities and Characteristics of Members Belonging to Bacillaceae Family. World J. Microbiol. Biotechnol. 2017, 33, 118. [Google Scholar] [CrossRef] [PubMed]
- Koerdt, A.; Gödeke, J.; Berger, J.; Thormann, K.M.; Albers, S.-V. Crenarchaeal Biofilm Formation under Extreme Conditions. PLoS ONE 2010, 5, e14104. [Google Scholar] [CrossRef]
- Li, F.; Xiong, X.-S.; Yang, Y.-Y.; Wang, J.-J.; Wang, M.-M.; Tang, J.-W.; Liu, Q.-H.; Wang, L.; Gu, B. Effects of NaCl Concentrations on Growth Patterns, Phenotypes Associated with Virulence, and Energy Metabolism in Escherichia coli BW25113. Front. Microbiol. 2021, 12, 705326. [Google Scholar] [CrossRef]
- Ferreira, R.B.R.; Ferreira, M.C.S.; Glatthardt, T.; Silvério, M.P.; Chamon, R.C.; Salgueiro, V.C.; Guimarães, L.C.; Alves, E.S.; dos Santos, K.R.N. Osmotic Stress Induces Biofilm Production by Staphylococcus epidermidis Isolates from Neonates. Diagn. Microbiol. Infect. Dis. 2019, 94, 337–341. [Google Scholar] [CrossRef]
- Pemmaraju, S.C.; Padmapriya, K.; Pruthi, P.A.; Prasad, R.; Pruthi, V. Impact of Oxidative and Osmotic Stresses on Candida albicans Biofilm Formation. Biofouling 2016, 32, 897–909. [Google Scholar] [CrossRef]
- Philips, J.; Rabaey, K.; Lovley, D.R.; Vargas, M. Biofilm Formation by Clostridium Ljungdahlii Is Induced by Sodium Chloride Stress: Experimental Evaluation and Transcriptome Analysis. PLoS ONE 2017, 12, e0170406. [Google Scholar] [CrossRef] [PubMed]
- Kent, A.G.; Garcia, C.A.; Martiny, A.C. Increased Biofilm Formation Due to High-Temperature Adaptation in Marine Roseobacter. Nat. Microbiol. 2018, 3, 989–995. [Google Scholar] [CrossRef] [PubMed]
- Bhargava, N.; Sharma, P.; Capalash, N. N-Acyl Homoserine Lactone Mediated Interspecies Interactions between A. baumannii and P. aeruginosa. Biofouling 2012, 28, 813–822. [Google Scholar] [CrossRef] [PubMed]
- Sun, Z.; He, X.; Brancaccio, V.F.; Yuan, J.; Riedel, C.U. Bifidobacteria Exhibit LuxS-Dependent Autoinducer 2 Activity and Biofilm Formation. PLoS ONE 2014, 9, e88260. [Google Scholar] [CrossRef] [PubMed]
- Roy, P.K.; Ha, A.J.-W.; Mizan, M.F.R.; Hossain, M.I.; Ashrafudoulla, M.; Toushik, S.H.; Nahar, S.; Kim, Y.K.; Ha, S.-D. Effects of Environmental Conditions (Temperature, PH, and Glucose) on Biofilm Formation of Salmonella enterica Serotype Kentucky and Virulence Gene Expression. Poult. Sci. 2021, 100, 101209. [Google Scholar] [CrossRef]
- Hiramatsu, R.; Matsumoto, M.; Sakae, K.; Miyazaki, Y. Ability of Shiga Toxin-Producing Escherichia coli and Salmonella Spp. To Survive in a Desiccation Model System and in Dry Foods. Appl. Environ. Microbiol. 2005, 71, 6657–6663. [Google Scholar] [CrossRef] [PubMed]
- Deng, Y. Influence of Temperature and PH on Survival of Escherichia coli O157:H7 in Dry Foods and Growth in Reconstituted Infant Rice Cereal. Int. J. Food Microbiol. 1998, 45, 173–184. [Google Scholar] [CrossRef] [PubMed]
- Keene, W.E. An Outbreak of Escherichia coli 0157:H7 Infections Traced to Jerky Made from Deer Meat. JAMA J. Am. Med. Assoc. 1997, 277, 1229. [Google Scholar] [CrossRef]
- Paton, A.W.; Ratcliff, R.M.; Doyle, R.M.; Seymour-Murray, J.; Davos, D.; Lanser, J.A.; Paton, J.C. Molecular Microbiological Investigation of an Outbreak of Hemolytic-Uremic Syndrome Caused by Dry Fermented Sausage Contaminated with Shiga-like Toxin-Producing Escherichia coli. J. Clin. Microbiol. 1996, 34, 1622–1627. [Google Scholar] [CrossRef]
- Ryu, J.-H.; Deng, Y.; Beuchat, L.R. Survival of Escherichia coli O157:H7 in Dried Beef Powder as Affected by Water Activity, Sodium Chloride Content and Temperature. Food Microbiol. 1999, 16, 309–316. [Google Scholar] [CrossRef]
- Møretrø, T.; Heir, E.; Mo, K.R.; Habimana, O.; Abdelgani, A.; Langsrud, S. Factors Affecting Survival of Shigatoxin-Producing Escherichia coli on Abiotic Surfaces. Int. J. Food Microbiol. 2010, 138, 71–77. [Google Scholar] [CrossRef] [PubMed]
- Heukelekian, H.; Heller, A. Relation between Food Concentration and Surface for Bacterial Growth. J. Bacteriol. 1940, 40, 547–558. [Google Scholar] [CrossRef] [PubMed]
- Kuda, T.; Nakano, A.; Takahashi, H.; Kimura, B. Effect of the Quantities of Food Residues on the Desiccation Resistance of Spoilage Lactic Acid Bacteria Adhered to a Stainless Steel Surface. Food Control 2016, 68, 40–44. [Google Scholar] [CrossRef]
- Carrascosa, C.; Raheem, D.; Ramos, F.; Saraiva, A.; Raposo, A. Microbial Biofilms in the Food Industry—A Comprehensive Review. Int. J. Environ. Res. Public Health 2021, 18, 2014. [Google Scholar] [CrossRef]
- Iñiguez-Moreno, M.; Gutiérrez-Lomelí, M.; Avila-Novoa, M.G. Kinetics of Biofilm Formation by Pathogenic and Spoilage Microorganisms under Conditions That Mimic the Poultry, Meat, and Egg Processing Industries. Int. J. Food Microbiol. 2019, 303, 32–41. [Google Scholar] [CrossRef]
- Mettler, E.; Carpentier, B. Variations over Time of Microbial Load and Physicochemical Properties of Floor Materials after Cleaning in Food Industry Premises. J. Food Prot. 1998, 61, 57–65. [Google Scholar] [CrossRef]
- Williams, A.P.; Avery, L.M.; Killham, K.; Jones, D.L. Persistence of Escherichia coli O157 on Farm Surfaces under Different Environmental Conditions. J. Appl. Microbiol. 2005, 98, 1075–1083. [Google Scholar] [CrossRef]

| Biofilm Class 1 | Generic E. coli | STEC 2 |
|---|---|---|
| 0, non-biofilm former | 45 | 92 |
| 1, weak | 4 | 4 |
| 2, moderate | 2 | 20 |
| 3, strong | 4 | 10 |
| 4, very strong | 10 | 0 |
| 5, extremely strong | 48 | 2 |
| Primer Set | Sequence |
|---|---|
| uidA | F: 5′ TGGTAATTACCGACGAAAACGGC 3′ |
| R: 5′ ACGCGTGGTTACAGTCTTGCG 3′ |
Disclaimer/Publisher’s Note: The statements, opinions and data contained in all publications are solely those of the individual author(s) and contributor(s) and not of MDPI and/or the editor(s). MDPI and/or the editor(s) disclaim responsibility for any injury to people or property resulting from any ideas, methods, instructions or products referred to in the content. |
© 2024 by the authors. Licensee MDPI, Basel, Switzerland. This article is an open access article distributed under the terms and conditions of the Creative Commons Attribution (CC BY) license (https://creativecommons.org/licenses/by/4.0/).
Share and Cite
Javed, M.Q.; Kovalchuk, I.; Yevtushenko, D.; Yang, X.; Stanford, K. Relationship between Desiccation Tolerance and Biofilm Formation in Shiga Toxin-Producing Escherichia coli. Microorganisms 2024, 12, 243. https://doi.org/10.3390/microorganisms12020243
Javed MQ, Kovalchuk I, Yevtushenko D, Yang X, Stanford K. Relationship between Desiccation Tolerance and Biofilm Formation in Shiga Toxin-Producing Escherichia coli. Microorganisms. 2024; 12(2):243. https://doi.org/10.3390/microorganisms12020243
Chicago/Turabian StyleJaved, Muhammad Qasim, Igor Kovalchuk, Dmytro Yevtushenko, Xianqin Yang, and Kim Stanford. 2024. "Relationship between Desiccation Tolerance and Biofilm Formation in Shiga Toxin-Producing Escherichia coli" Microorganisms 12, no. 2: 243. https://doi.org/10.3390/microorganisms12020243
APA StyleJaved, M. Q., Kovalchuk, I., Yevtushenko, D., Yang, X., & Stanford, K. (2024). Relationship between Desiccation Tolerance and Biofilm Formation in Shiga Toxin-Producing Escherichia coli. Microorganisms, 12(2), 243. https://doi.org/10.3390/microorganisms12020243

